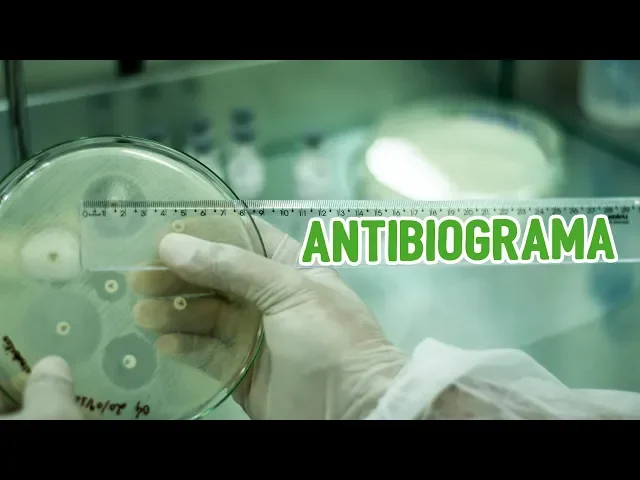

nos últimos dias tenho postado vários vídeos aqui no canadá e méxico a respeito de microbiologia clínica e o vídeo de hoje não vai ser diferente como você já viu pelo título do vídeo aqui eu vou falar sobre o antibiograma como fazer e interpretá lo então pegue seu jaleco evento miguel a prática vai começar veja todos bem vindos este é o caso do méxico o melhor canal para ter informação a respeito de biomedicina aqui no youtube meu nome é marcelo oliveira e sempre que eu posso eu dedico uns minutinhos do meu dia para falar de biomedicina
pra vocês no vídeo de hoje que vai ser meio de um blog um deles blog eu vou mostrar como é que foi uma aula o preparo de uma aula para fazer o antigo grama ontem à noite os alunos fizeram antibiograma fizeram uns e meio tudo certinho tá e hoje eu vou fazer é o passo a passo durante o programa pra vocês pra vocês entendam como é que funciona a técnica e tudo mais lembrando que esse vídeo ele está ele está sendo feito com base nos últimos manuais durante o programa que tem saído que foi de
2018 já inclusive o material que eu vou usar aqui é o material básico para onde programa vocês vão acompanhar agora mas não se esquece se você ainda não é esse o caso do médico se inscreve e se você ainda não teve o auxílio de notificação ativa porque eu preciso que você saiba dos novos vídeos vai sair por aqui [Música] gente pra vocês entenderem como vai funcionar eu vou colocar dentro dessa capela de vidro é uma capela de vidro todo transparente a gente chama de uma capela em chama de capela de idade porque é o que
eu faço o procedimento de que os alunos vejam tudo lá por fora fica bem tranquilo aqui também uma salinha ó uma sala de tipo de esterilização e de preparar o material então aqui dentro um local ideal para fazer esse exemplo eu vou colocar o material aqui dentro a câmera vai ficar aqui por fora no vidro pra vocês verem tudo o que irei tinho e forma ocorreu me contaminar a câmera também para começar o nosso ensaio a gente precisa tomar todos os cuidados possíveis com os itens de ver o segurança então usar a luva cobrir com
jaleco é é o mínimo que a gente pode fazer para evitar que a gente acabe traz derramando a bactéria na pele e causando algum dano ou até mesmo tirando alguma bactéria da nossa microbiota colocando no meio e causando contaminação cruzada e uma identificação errônea e provavelmente um diagnóstico também errado o outro item que é importante lembrar também aqui todo cuidado é pouco afinal nós estamos diante de amostras clínicas amostras biológicas e que precisam de muito cuidado no manuseio para começar o nosso ensaio do antibiograma nós precisamos suspender a nossa bactéria em salina externo então por
que nós fizemos pegamos um tubinho colocamos de 3 a 5 m anges de salina ou soro fisiológico 0 85% colocamos protocolava durante 15 minutos povo 21 121 graus e após o resfriamento a gente vai fazer a suspensão da nossa bactéria todo o material aqui é esterilizado tá bom então fiquem atentos a isso também o primeiro passo é fazer uma suspensão da nossa bactéria em salina é comparando a nossa suspensão com a escala 00.5 de mac fome então você vai pagar a sua alça bacteriológica que é estéreo você vai pegar um pouquinho da sua colônia em
ter muito cuidado para não arrastar o meio e acabar contaminando a nossa salina com o material do meio lembrando também que o meio que a gente utiliza para fazer essa cultura é o águia nutriente ou em alguns casos você também pode utilizar o meu lindo o oma outra informação que é muito importante também é que essa cultura que você vai utilizar para fazer a suspensão ela tem que ser recente então ela tem que ter no máximo 24 horas de idade de culto você vai fazer a suspensão vai chacoalhar aqui para poder verificar o quanto ela
vai tudo vá comparar com a escala de uma falange e seguir seu procedimento algumas pessoas podem perguntar se essa classificação da escala do mec fala de 0.5 ela é visual e sim é visual mesmo este pode ser feito espectrofotômetro é claro mas geralmente a gente faz a classificação visual porque ela é muito prático e ela foi feito pra isso após a suspensão ficar pronto você vai esperar aproximadamente 15 minutos vai pegar uma placa de petri grande de 150 por 90 milímetros você vai identificar nas bordas da placa porque quando formar o aluno vai ficar mais
fácil de você identificar já que você identificou a placa na borda geralmente você coloca um código do paciente o nome ao nome de quem fez geralmente algumas pessoas colocam a data do dia e vai seguir com o procedimento então sempre é colocando nomeando aquela placa pela borda ok agora o próximo passo é seguir com o seu e mail você vai pegar um suave estéreo tá fabri pelo outro lado que não é o do algodão da china você vai mergulhar se suave na solução salina que você fez na suspensão da bactéria em salina que você fez
vai deixar ela por alguns segundos lá dentro e em seguida você vai tirar s se sabe vai aprender um pouquinho na parede do tubo para tirar o excesso e vai fazer seguir com o semeio propriamente dito o cemei geralmente é feito quando você faz um ciclo nas bordas da placa lembrando que pra fazer semana você vai fazer esses riscos de ponta a ponta da placa os riscos têm que ser um juntinho do outro tá não é como os riscos dos e meio que a gente faz lá no início dos testes é em microbiologia não você
meio é sempre assim um pertinho do outro lembrando que você tem que fazer 5 c meios nas cincos treinamentos então você vai fazer um por cima deles e faz o outro até você quantificar 5s é mesmo por cima do gol [Música] você vai esperar mais 15 minutinhos para que aquela suspensão aquele líquido que você colocou na placa e vocês e mail ele acabe sendo absorvido um pouco pelo meio de cultura e você vai agora fazer a escolha dos antibióticos [Música] [Aplausos] a escolha dos antibióticos e feitas com base na classificação da bactéria então se você
tem um staphylococcus aureus você vai usar determinados tipos de antibiótico se você tem uma pseudomonas outros antibióticos e daí por diante então o ideal é você sempre seguir as tabelas para poder você verificar quais antibióticos a estar para aquela bactéria que você tem jogado ali lembrando que essa bactéria foi determinada anteriormente ao estágio você fez alguma metodologia para identificar a bactéria é nesse caso nós utilizamos as metodologias da série bioquímica que eu mostrei no vídeo anterior oprah desponte biótico dentro do meio você vai pegar com a pinça estéreo um antibiótico apenas que vai colocar em
cima do meio tá você vai colocar o antibiótico no meio e vai apertar só um pouquinho sem encostar a pinça no meio de cultura logo em seguida você vai roubar pegar o próximo antibiótico e fazer o mesmo procedimento pega o disco coloca na placa lã balsa pega um outro disco coloca uma placa e daí por diante tá então você vai sempre pegar o disco só apertar um pouquinho colocar na placa e seguir o processo uma coisa que é importante dizer são os espaços entre um disco e outro tá não existe uma quantidade ideal de espaço
entre um desfile e outro tem gente que pede por dois centímetros três cêntimos não importa que depende também do tamanho da sua placa mas que você precisa entender é que esses espaços têm que ser equidistante estou seja à distância de um outro tem que ser basicamente a mesma para que quando forme o alô você consegue identificar e fazer a dimensão daquele a lu e depois leva para sua tabela pra comparar uma coisa que é muito comum de acontecer é colocar o antibiótico desistir de tirar ele do lugar e colocar em outro lugar como eu mostrei
aqui pra vocês verem isso não pode acontecer tá depois que você coloca o antibiótico no meio é a unidade que tem no meio vai impregnar no papel e isso vai voltar para o meio de cultura quando isso é o antibiótico começa a ser difundido no meio de cultura você já não pode mais tirar o disco do meio e isso não pode acontecer então não pode colocar o antibiótico tirar mudar de posição se não você vai ter um halo grande um aluno normal no local onde taupo disco e um outro algo que você colocou quando o
disco caio anteriormente isso não pode acontecer depois que você colocou os riscos você confere se está tudo bonitinho está tudo anotado se nenhum disco caiu leva sua placa pra estufa a 35 mais ou menos 2 graus então 37 graus geralmente lembrando que a sua placa de ficar de cabeça pra baixo pra que não forme umidade na borda na tampa da placa e isso não caia dentro da sua cultura e possa ter algum tipo de problema na no halo ou na cultura propriamente dita passadas 24 horas você vai fazer a leitura do seu antibiograma tá então
eu tenho aqui três placas olha essa primeira ela tenha vários alunos essa segunda já não tem tantos jogos assim é muito provável que essa bactéria tem alguma resistência e essa outra que também tem vários alunos alguns maiores alguns menores o que você vai fazer você vai fazer a quantificação desse aluno então você vai pegar o antibiótico que você colocou ali vai fazer a dimensionar momento do aluvião anotar isso num papelzinho tá e vai levar para uma tabela para comparar então por exemplo essa placa que eu fui mostrando pra vocês agora é uma placa staphylococcus aureus
então eu vou pegar minha tabela linha verificar quais são os tamanhos dos alunos do estafilococo usados para cada antibiótico e vou comparar e depois determinar se ele é sensível o resistente depois disso você expresse seu lado da forma correta né dizendo quais são os antibióticos adequados e quais os que não são e a partir daí o médico vai pegar o seu laudo vai verificar o que você falou a ele que são os antibióticos adequados ou não e ele vai seguir com a terapêutica do paciente com base no que você falou olha a responsabilidade em gente
então eu estou agora que você já sabe como que faz oito programa e como faz a leitura de modo geral eu sugiro que vocês dêem uma olhadinha no manual que tem aqui em baixo que é uma norma mais atualizada respeitar a leitura durante programa de como fazer e como interpretado como organizar apesar de parecer muito simples a gente tem que tomar muito cuidado às vezes não é tão simples assim então é isso eu vou ficando por aqui espero que tenham gostado desse vídeo caso você queira se aprofundar um pouco mais no mundo da microbiologia eu
vou deixar o link aqui embaixo do meu curso que você pode fazer se você curtir é eu tenho certeza que você vai gostar do curso que ele está bem de idade está bem bem bem bastante vídeo bastante imagem eu espero que vocês gostem desse vídeo espero que você tenha se inscrito no canal caso você ainda não fosse inscrito e se você não deixou a jóia aproveitou deixa agora se você gostou deste vídeo eu vou esperar você para os próximos vídeos se você atinge facilmente notificação eu vou ficando por aqui e até a próxima